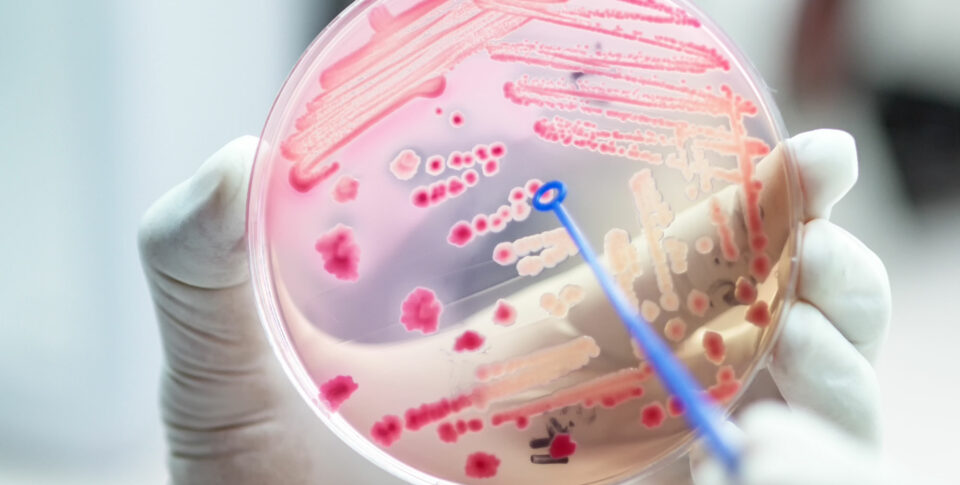

Indo-Swiss Innovation Platform
In October, Swissnex in India is hosting an Indo-Swiss AMR symposium experts across the globe will come together to discuss the potential public health crisis that is Anti-Microbial Resistance.
A silent killer
Anti-Microbial Resistance or AMR kills slowly and creates an illusion that it does not need to be addressed urgently.
India is more vulnerable than most other countries because of its sheer population, but its scientific laboratories—with advanced R&D—are also where key innovations are likely to develop. In fact, the Indian government has pledged strategic action to, among other efforts, collaborate on AMR on a global and national level, as well as promote investments for AMR research and innovation.
-
What is AMR?
Simply put, antimicrobial resistance or AMR is when microbes. What happens if microbes defeat the antibiotics, is that they can mutate and become more aggressive, requiring ingestion of stronger antibiotics. This is where Swissnex in India comes in—as a mediator that helps various stakeholders collaborate and discuss possible innovative measures to find a way and tackle this concerning crisis.
-
How does this affect us?
AMR has the potential to disrupt our lives in the near future. Antibiotics are used to treat diseases like tuberculosis, pneumonia, food poisoning, urinary tract infections, sexually transmitted diseases like HIV, and strep throat among others. If the disease-causing bacteria survive the strongest antibiotics, this could lead to serious complications eventually causing death. AMR is very much like climate change—it kills slowly, and therefore creates an illusion that it does not need to be addressed, or addressed urgently.
Tackling AMR
We encourage and support collaborations that address some of the most pressing and time-sensitive issues that affect India and Switzerland, like AMR.
Bringing stakeholders together
By bringing together people from these varied fields, we hope to enable discussions about their respective roadblocks and collaborate with each other to find the best possible solutions. Addressing the AMR crisis requires cross-border efforts and these include developing new technologies, new treatments, and finding new ways to change public behaviour.
-
Join experts from around the world
October; we're hosting an Indo-Swiss AMR symposium, where 50 experts—25 from each country—from research institutions, startup innovation, nonprofits, and public health will get together for three days and deliberate over their obstacles.
How can I do my bit to prevent AMR?
Sometimes, the smallest step can have the deepest impact.
-
0
1
A simple start could be to not take antibiotics without consulting your doctor.
-
0
2
Make sure to not quit your dosage halfway through, even if you're feeling better.
-
0
3
Dispose of antibiotics safely. Mix them with unsavoury food, seal in a bag and discard in the trash.